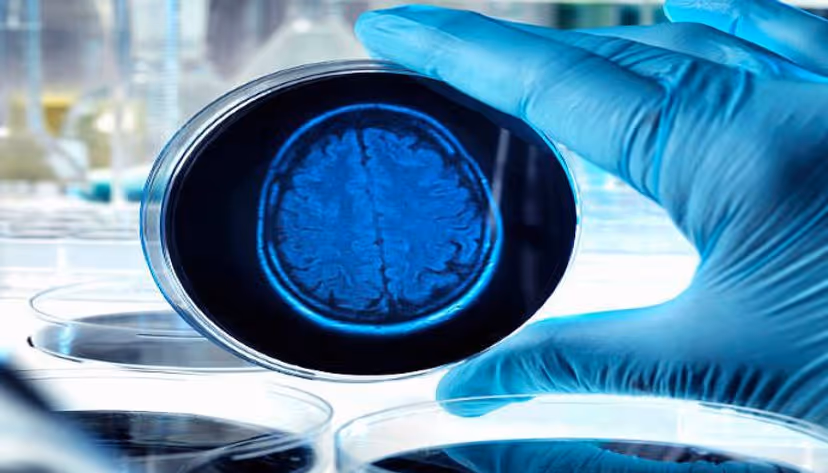

How Brain-in-a-Dish Technology Can Impact the Treatment of MDD
The pathway to effective treatment of MDD may be improved by multifaceted diagnostic tools, including but not limited to brain-in-a-dish technology.
The pathway to effective treatment of MDD may be improved by multifaceted diagnostic tools, including but not limited to brain-in-a-dish technology.
According to the WHO, major depressive disorder (MDD) is the most common illness, affecting approximately 280 million people worldwide. That said, treating depression presents a unique challenge for providers. With several medications available and a lack of understanding surrounding the efficacy of these medications, many providers must go through a trial-and-error treatment journey to provide patients with care. New technologies and multifaceted testing, such as brain-in-a-dish testing, may minimize the path to finding an effective antidepressant.
PharmaNewsIntelligence interviewed Talia Cohen Solal, PhD, CEO, and co-founder of NeuroKaire (formerly Genetika+), to discuss major depressive disorder (MDD), NeuroKaire — a diagnostic tool, and its benefits.
NEUROKAIRE BASICS
To start, Solal explained that NeuroKaire is not just a singular test but a battery of tests to determine which antidepressant would work best for a patient with major depressive disorders.
“NeuroKaire is a blood test and questionnaire that a physician would use to help predict which antidepressant is best for each patient,” shared Solal.
The current prescription method for antidepressants is trial and error. “When a patient suffers from major depression, there are around 70 medications that the physician can choose from. The patient takes weeks to months to years to test different drugs in their body. Each drug takes four to six weeks to test, so it's a difficult and life-threatening time,” she noted.
“The Genetika+ blood test and questionnaire, called NeuroKaire, is a test the patient can take, which the physician can use to prescribe the proper medication,” continued Solal.
Three Components of NeuroKaire
As previously mentioned, NeuroKaire is a battery of tests examining multiple components affecting patients’ outcomes with specific antidepressants.
“The experience for the patient is just like a regular blood draw. From that, providers have three components to look at. One is regular pharmacogenetics, which tells a physician whether the patient will be able to process that drug and whether it can make it past the liver to the brain,” said Solal.
In addition to the basic pharmacogenetics based on the blood draw, a questionnaire is conducted as a part of NeuroKaire. She notes, “then there are also the AI-based algorithms around the patient history used as predictors for whether a patient will respond to the medication.”
Aside from these relatively basic portions of the test, Solal shared another, less conventional approach that the test uses. “Most uniquely, Genetika+ has developed its brain in a dish screening platform. Using each patient’s blood sample, we create our brain in a dish — almost like a biopsy of the brain except noninvasive. Then, we expose it to all the different antidepressants to see which antidepressant has the best impact on each patient,” began Solal.
“We combine these three pillars to provide an overall recommendation for the physician on which drugs would benefit the patient and which drugs they should avoid. And this platform altogether is the NeuroKaire platform, but the experience for the patient is a blood draw. The experience for the physician is a blood draw and a PDF result telling them which antidepressant's best for their patient,” she remarked.
NeuroKaire Background
PharmaNewsIntelligence asked Solal to expand on the reasonings behind this approach and how she and her team decided this would be a helpful tool. “I was using a more basic version of the brain in a dish platform during my academic studies and saw the potential of this platform for clinical use,” revealed Solal. “This platform is well-validated. Many studies show the ability to successfully generate neurons, including Genetika+’s own, published in Translational Psychiatry in 2021, showing how you can use these brains in a dish to replicate the patient's drug response in a dish. We've been using patient samples from prestigious clinical trials to develop and validate the predictive accuracy of our platform.”
ISSUES IN TREATING MAJOR DEPRESSIVE DISORDER
PharmaNewsIntelligence asked Solal to discuss current issues in treating major depressive disorders to understand this tool's clinical implications better.
“Unfortunately, there are no clear guidelines on which drug is best for each patient or which drug to begin with. So, clinicians use best practices, experience, and instinct to make that decision,” she responded. “But overall, 63% of the time, the patient needs a drug switch, meaning that the process is not working very well. Physicians are struggling with patients that take months and years to find the right treatment. Some highly treatment-resistant patients don't even make it there and maybe start on ECT or more difficult therapies. They have less successful outcomes than they might like in practice.”
In addition to inconsistent patient outcomes and the burden that patients experience on their journey to find the proper medication, this process also severely hinders provider workflow. Rather than being able to treat multiple patients effectively, providers spend more time on a handful of patients who have not yet received the proper treatments. This, in turn, leads to longer wait times and reduced access to mental healthcare.
“Because it can take many of these patients months to years to find the right drug, and they keep needing to go back to those same physicians and taking more of their time, by getting patients to the right drug faster, we'll be reducing those wait times in an absolute sense to improving that. And unfortunately, they won't run out of patients anytime soon.
CARE COSTS
In addition to understanding how this tool can alter treatment routes for providers and patients, PharmaNewsIntelligence was curious to know how the cost of this tool compared to the costs of the traditional diagnostic course.
According to the American Psychiatric Association, the economic burden of MDD in the United States in 2018 totaled $236 billion. These care costs combine direct costs, such as medication and medical services, workplace costs, and suicide-related costs.
Solal told PharmaNewsIntelligence, “the cost structure of Genetika+ is keeping up with alternatives available on the market today. Based on current practice, we won't be changing those costs.”
She added, “generally speaking, because the cost of a patient suffering from major depression annually who's not being well treated is twice as high as a patient who is being well treated, the cost saving to the insurance provider or the payer is around $7,000 per patient. So overall, our costs are well beneath that, leading to dramatic savings for the healthcare system.”
IMPLICATIONS
As new devices and diagnostic tools come to market, the implications for the healthcare system are endless. PharmaNewsIntelligence asked Solal to discuss the real-world and research significance of this diagnostic tool.
She shared that the company has a sector that focuses on drug development and repurposing. “Because our platform allows researchers to use a kind of brain biopsy, providers screen for whether a drug is going to work,” began Solal. “We can also compare it to other groups of patients who've responded to less similar drugs or haven't responded to other drugs, and we can help with the development of biomarkers for specific populations of patients who might be responders.”
This knowledge can be precious in a clinical setting, especially in cases where patients are more critical. “The world is moving toward a model of precision medicine with new research and drugs. It's no longer one size fits all — it's a precision medicine model,” concluded Solal.
As the healthcare industry progresses into the era of precision medicine, researchers and other sector members should consider diagnostic tools that analyze patients individually.
Contact Us
78 John Miller Way,
Kearny, NJ 07032, USA
Yigal Alon Street 126
Tel Aviv-Yafo, Israel
